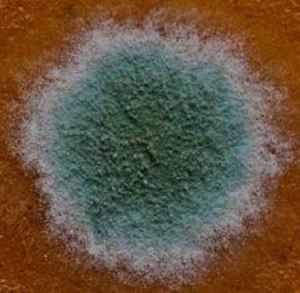

Pentru a înțelege despre ce visează, acordați atenție locului de apariție sau produselor rănite. Acordați atenție cât de importante sunt pentru dvs. și ce emoții vă confruntați într-un vis. Aceasta este ceea ce mucegaiul cel mai adesea visează la diferite persoane.
În interior pe pereți
Acest vis are mai multe sensuri. Rolul cheie într-un astfel de vis este jucat de ceea ce este destinat, vechea casă sau cea nouă și modul în care este conectată cu tine într-un vis sau în realitate. Apoi, puteți descifra cu ușurință visul și înțelegeți exact ce înseamnă această ciupercă în viziunea ta de noapte.

Forma neagră într-un vis prezice alterări, un efect negativ magic sau o boală care poate fi foarte periculoasă. O nuanță întunecată poate prezice diferite emoții și incidente proaste: persecuție, jaf, trădarea unui iubit.
Dacă visezi că vă cumpărați o casă nouă sau un apartament pentru familia ta sau locuiesc împreună cu iubitul ei, modern mucegai interpretare vis pe pereți și tavan interpretat ca ceea ce relația în sine poate da o fisură.
Cumpărarea unei case înseamnă planurile tale de viitor, de a trăi împreună si dincolo. În cazul în care fisuri și mucegai distruge frumusețea, bucuria inovației, cartea de vis spune ca acest vis este în pericol, atunci, că, din cauza certurilor nesinceritate, insulte reciproce și pretinde că totul colaps. Soții visele pot prezice moartea unei persoane dragi, sau că fericirea va fi în curând umbrită de trădare, trădare, sau înrămate.
Cumpărați o casă cu mucegai pe pereți - o boală periculoasă sau o schimbare de planuri pentru viitor. Cu toate acestea, curățarea zidurilor și scăderea lor într-un vis este un semn foarte bun, oferindu-vă o mulțime de lucruri bune.

Dar nu va fi multă durere de la asta, dacă mucegaiul nu ocupă mult spațiu și este ușor de curățat. Dacă putregaiul negru neplăcut ocupă mult spațiu, așteptați problemele mari.
Un astfel de vis poate prezice pericolul atât pentru bunăstarea materială, cât și pentru sănătate și chiar pentru viață. Acest vis poate provoca o boală periculoasă, jaf, agresiune, doliu în casă, vina făcută de un profesionist, furt sau multă durere și depresie, pericolul unui incendiu.

Uneori, cărțile moderne privind interpretarea viselor vă prefigurează o stare extrem de proastă, depresie, singurătate lungă și lacrimi. De obicei, visurile cu astfel de subiecte sunt invitați frecvenți de oameni care sunt pe punctul de a dispera și de bine, dacă într-un vis reușiți să părăsiți o casă abandonată sau o structură a unui astfel de plan.
Pe produsele alimentare

În cazul în care ea a fost pe produsele din pește sau carne, feriți-vă de boală, și cereale, legume, brânză (nu Dorblu și altele asemenea) și pâine, rasfatat de o ciuperca, ai prevestește pierderi financiare sau durerea asociată cu pierderea, amenzi sau pierderii într-o chestiune importantă .
Aspectul petelor albastre fuzzy pe aceste accesorii, săpun sau în baie înseamnă în general o deteriorare a sănătății sau a bolii. Există o brânză cu vase albastre nobile într-un vis și fructe proaspete vă prezint comunicare plăcută, bucurie și plăceri senzuale.